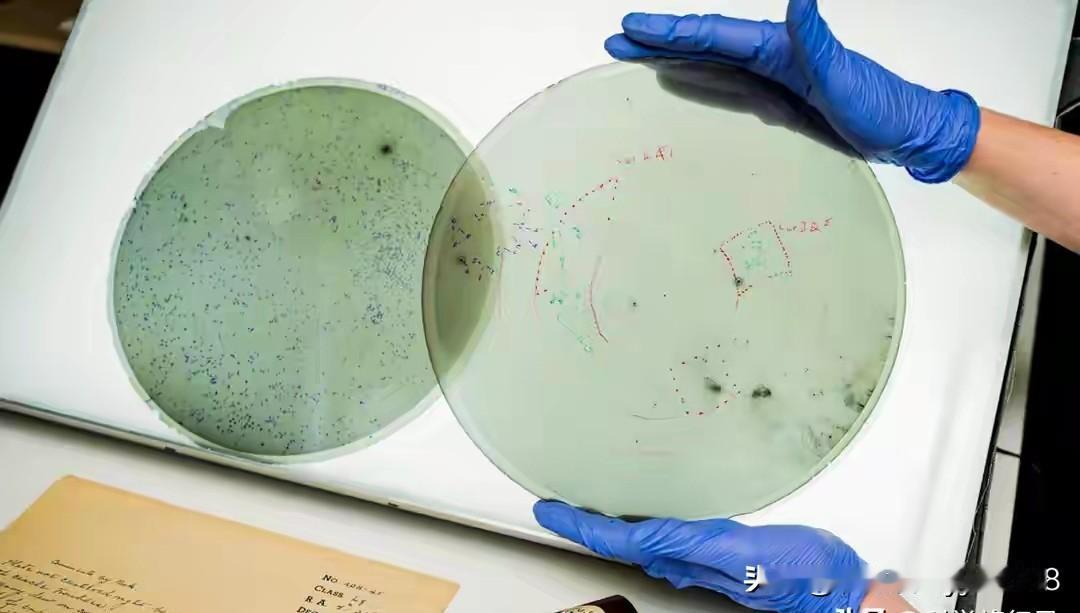

人类核爆真的引来宇宙监视?NASA联合多国科研团队,用几十年的天文观测数据,得出了让人后背发凉的结果。
VASCO计划把百年天文底片和现在的星空图逐一比对,筛查过六亿多天体后,发现有十五万个曾经存在的恒星,毫无征兆地消失了。
按常理,恒星消亡一定会有超新星爆发,留下清晰痕迹,而这些星体,就像被人从星图上直接抹掉一样。
更让人想不通的是,上世纪四五十年代的天文底片里,多次出现短促、锐利的闪光,不留拖尾、不重复出现,完全不像自然天象。
时间一对就发现,这段时间正是全球核试验最密集的阶段,数据显示,核爆发生时,这类异常闪光概率大幅上升,明显不是巧合。
科研人员排除了恒星坍缩、底片故障、大气干扰等所有可能,目前最受关注的推测就是,这些闪光很可能是地外智能的探测信号。
1956年一次大型核试验后,这些异象突然全部消失,就像监测者停止了观察。
人类总在地球上计较得失、相互竞争,却没意识到,我们的一举一动,可能早已被宇宙中未知的存在看在眼里。
比起内部纷争,人类更该团结起来,共同面对这片未知的星空。
你觉得这些诡异的宇宙闪光,和外星文明有关吗?
宇宙未解之谜 外星文明 天文发现 人类命运共同体